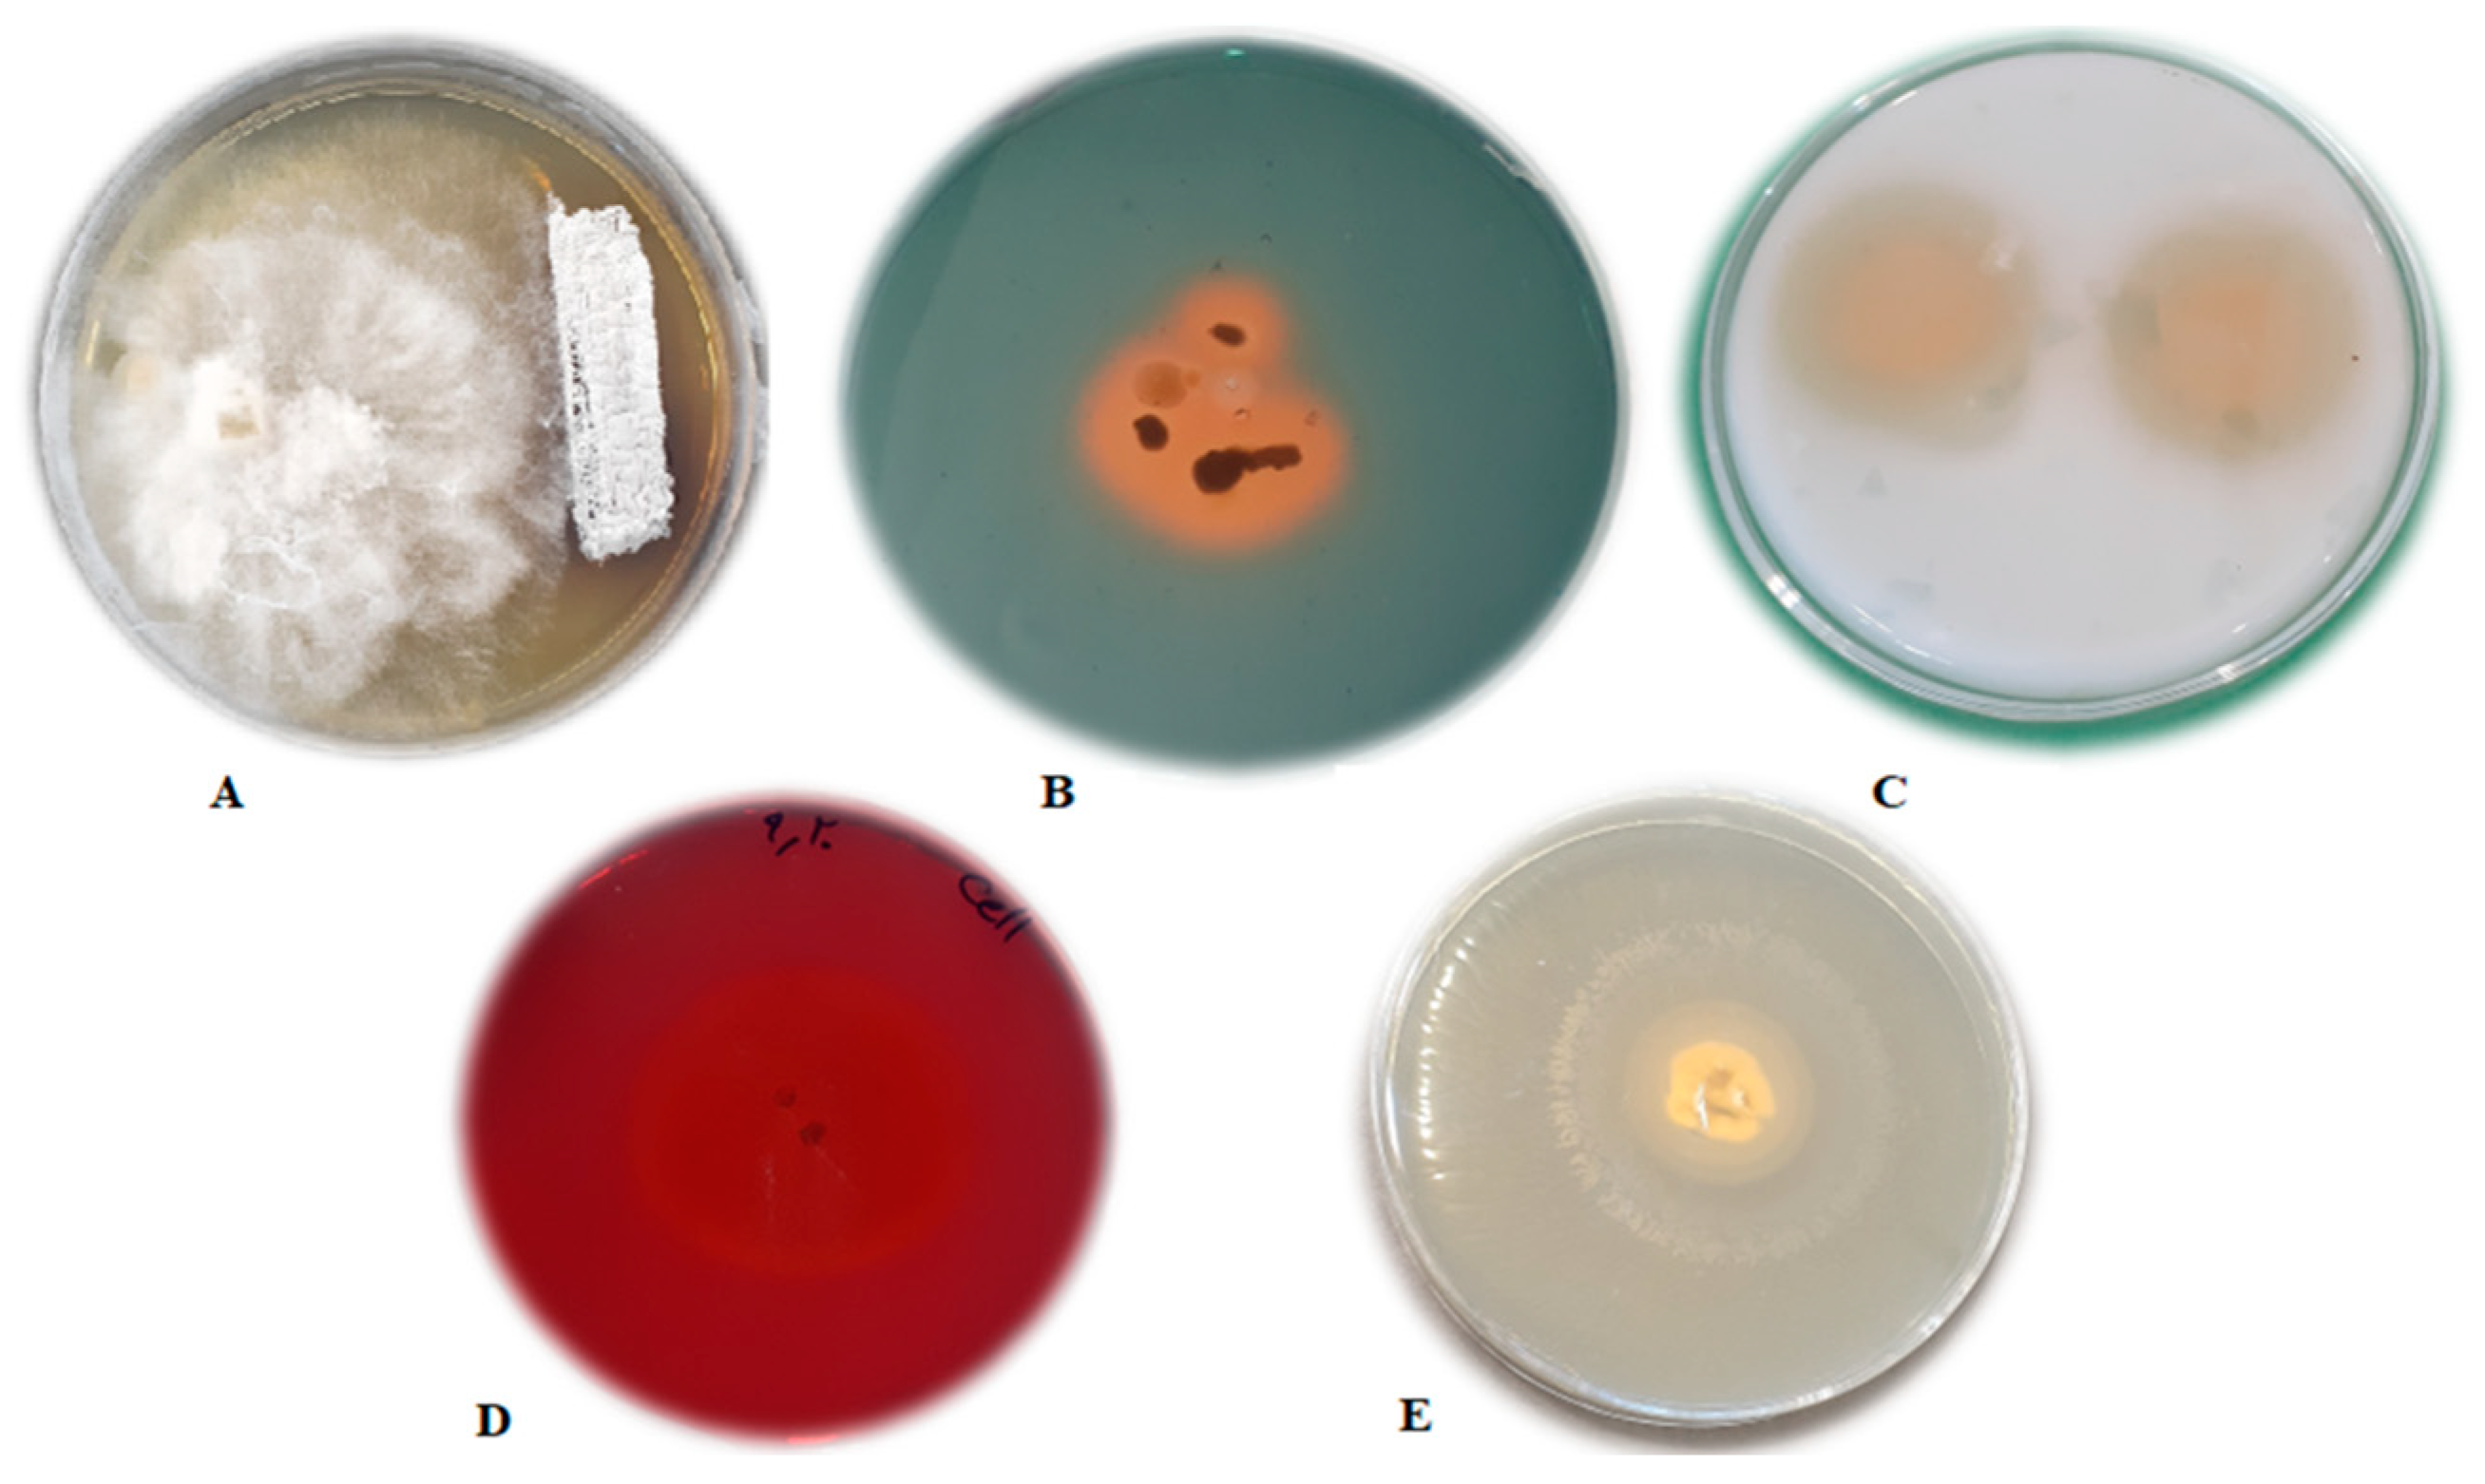
Agronomy 12 00655 g001

A Novel Route for Double-Layered Encapsulation of Streptomyces fulvissimus Uts22 by Alginate–Arabic Gum for Controlling of Pythium aphanidermatum in Cucumber
Abstract
1. Introduction
2. Materials and Methods
2.1. In Vitro Antifungal Assay
2.2. Screening of Plant Growth Promoting Activities
2.2.1. Siderophore Production
2.2.2. Auxin Production
2.3. Hydrolytic Enzyme Production
2.3.1. Cellulase Assay
2.3.2. Protease Production
2.3.3. Production of Lipase
2.4. Preparation and Characterization of Microcapsules
2.4.1. Surface Morphology of Microcapsules
2.4.2. FTIR Analysis
2.4.3. X-ray Diffraction
2.4.4. In Vitro Release of S. fulvissimus Uts22 from Microcapsules
2.4.5. Determination of S. fulvissimus Uts22 in the Cucumber Root
2.5. Greenhouse Experiments
2.6. Statistical Analysis
3. Results and Discussion
3.1. In Vitro Antifungal Assay
3.2. Screening of Plant Growth Promoting Activities
3.2.1. Siderophore Production
Auxin Production
3.2.2. Hydrolytic Enzyme Production
3.3. Preparation and Characterization of Microcapsules
3.3.1. Encapsulation Efficiency
3.3.2. Surface Morphology of Microcapsules
3.3.3. FTIR Analysis
3.3.4. X-ray Diffraction
3.3.5. In Vitro Release of S. fulvissimus Uts22 from Microcapsules
3.3.6. Determination of S. fulvissimus Uts22 in the Cucumber Root
3.4. Greenhouse Experiments
4. Conclusions
Author Contributions
Funding
Institutional Review Board Statement
Informed Consent Statement
Data Availability Statement
Acknowledgments
Conflicts of Interest
References
- Ni, L.; Punja, Z.K. Management of Fungal Diseases on Cucumber (Cucumis sativus L.) and Tomato (Solanum lycopersicum L.) Crops in Greenhouses Using Bacillus subtilis. In Bacilli and Agrobiotechnology: Phytostimulation and Biocontrol. Bacilli in Climate Resilient Agriculture and Bioprospecting; Islam, M., Rahman, M., Pandey, P., Boehme, M., Haesaert, G., Eds.; Springer: Cham, Switzerland, 2019. [Google Scholar]
- Halo, B.A.; Al-Yahyai, R.A.; Al-Sadi, A.M. Biological control of Pythium aphanidermatum-induced cucumber and radish damping-off by an endophytic fungus, Cladosporium omanense isolate 31R. Biocontrol. Sci. Technol. 2020, 31, 235–251. [Google Scholar] [CrossRef]
- Noble, R.; Coventry, E. Suppression of soil-borne plant diseases with composts: A review. Biocontrol. Sci. Technol. 2005, 15, 3–20. [Google Scholar] [CrossRef]
- Nega, A. Review on Concepts in Biological Control of Plant Pathogens. J. Biol. Agric. Healthc. 2014, 4, 33–55. [Google Scholar]
- Kaur, P.; Purewal, S.S. Biofertilizers and Their Role in Sustainable Agriculture. In Biofertilizers for Sustainable Agriculture and Environment; Giri, B., Prasad, R., Wu, Q.S., Varma, A., Eds.; Springer: Cham, Switzerland, 2019; Volume 55. [Google Scholar]
- Adnan, M.; Islam, W.; Shabbir, A.; Khan, K.; Ghramh, H.A.; Huang, Z.; Chen, H.Y.; Lu, G.-D. Plant defense against fungal pathogens by antagonistic fungi with Trichoderma in focus. Microb. Pathog. 2019, 129, 7–18. [Google Scholar] [CrossRef]
- Hu, D.; Li, S.; Li, Y.; Peng, J.; Wei, X.; Ma, J.; Zhang, C.; Jia, N.; Wang, E.; Wang, Z. Streptomyces sp. strain TOR3209: A rhizosphere bacterium promoting growth of tomato by affecting the rhizosphere microbial community. Sci. Rep. 2020, 10, 20132. [Google Scholar] [CrossRef]
- Chaiharn, M.; Theantana, T.; Pathom-Aree, W. Evaluation of Biocontrol Activities of Streptomyces spp. against Rice Blast Disease Fungi. Pathogens 2020, 9, 126. [Google Scholar] [CrossRef]
- Lobo, C.B.; Tomas, M.S.; Viruel, E.; Ferrero, M.A.; Lucca, M.E. Development of low-cost formulations of plant growth-promoting bacteria to be used as inoculants in beneficial agricultural technologies. Microbiol. Res. 2018, 219, 12–25. [Google Scholar] [CrossRef]
- Saberi-Riseh, R.; Moradi-Pour, M.; Mohammadinejad, R.; Thakur, V. Biopolymers for Biological Control of Plant Pathogens: Advances in Microencapsulation of Beneficial Microorganisms. Polymers 2021, 13, 1938. [Google Scholar] [CrossRef]
- Pour, M.M.; Saberi-Riseh, R.; Mohammadinejad, R.; Hosseini, A. Nano-Encapsulation of Plant Growth-Promoting Rhizobacteria and Their Metabolites Using Alginate-Silica Nanoparticles and Carbon Nanotube Improves UCB1 Pistachio Micropropagation. J. Microbiol. Biotechnol. 2019, 29, 1096–1103. [Google Scholar] [CrossRef]
- Berninger, T.; López, Ó.G.; Bejarano, A.; Preininger, C.; Sessitsch, A. Maintenance and assessment of cell viability in formulation of non-sporulating bacterial inoculants. Microb. Biotechnol. 2018, 11, 277–301. [Google Scholar] [CrossRef]
- Schoebitz, M.; López, M.D.; Roldán, A. Bioencapsulation of microbial inoculants for better soil-plant fertilization. A review. Agron. Sustain. Dev. 2013, 33, 751–765. [Google Scholar] [CrossRef]
- Riseh, R.S.; Ebrahimi-Zarandi, M.; Tamanadar, E.; Pour, M.M.; Thakur, V.K. Salinity Stress: Toward Sustainable Plant Strategies and Using Plant Growth-Promoting Rhizobacteria Encapsulation for Reducing It. Sustainability 2021, 13, 12758. [Google Scholar] [CrossRef]
- Albadran, H.A.; Chatzifragkou, A.; Khutoryanskiy, V.V.; Charalampopoulos, D. Stability of probiotic Lactobacillus plantarum in dry microcapsules under accelerated storage conditions. Food Res. Int. 2015, 74, 208–216. [Google Scholar] [CrossRef] [PubMed]
- D’Orazio, G.; Di Gennaro, P.; Boccarusso, M.; Presti, I.; Bizzaro, G.; Giardina, S.; Michelotti, A.; Labra, M.; La Ferla, B. Microencapsulation of new probiotic formulations for gastrointestinal delivery: In vitro study to assess viability and biological properties. Appl. Microbiol. Biotechnol. 2015, 99, 9779–9789. [Google Scholar] [CrossRef]
- Ke, Y.; Liu, G.S.; Wang, J.H.; Xue, W.; Du, C.; Wu, G. Preparation of carboxymethyl cellulose based microgels for cell encapsulation. Express Polym. Lett. 2014, 8, 841–849. [Google Scholar] [CrossRef]
- Keskin, N.O.S.; Celebioglu, A.; Sarioglu, O.F.; Uyar, T.; Tekinay, T. Encapsulation of living bacteria in electrospun cyclodextrin ultrathin fibers for bioremediation of heavy metals and reactive dye from wastewater. Colloids Surf. B Biointerfaces 2018, 161, 169–176. [Google Scholar] [CrossRef] [PubMed]
- Sarioglu, O.F.; Keskin, N.O.S.; Celebioglu, A.; Tekinay, T.; Uyar, T. Bacteria immobilized electrospun polycaprolactone and polylactic acid fibrous webs for remediation of textile dyes in water. Chemosphere 2017, 184, 393–399. [Google Scholar] [CrossRef] [PubMed]
- Riseh, R.S.; Skorik, Y.A.; Thakur, V.K.; Pour, M.M.; Tamanadar, E.; Noghabi, S.S. Encapsulation of Plant Biocontrol Bacteria with Alginate as a Main Polymer Material. Int. J. Mol. Sci. 2021, 22, 11165. [Google Scholar] [CrossRef]
- Pour, M.M.; Saberi-Riseh, R.; Mohammadinejad, R.; Hosseini, A. Investigating the formulation of alginate- gelatin encapsulated Pseudomonas fluorescens (VUPF5 and T17-4 strains) for controlling Fusarium solani on potato. Int. J. Biol. Macromol. 2019, 133, 603–613. [Google Scholar] [CrossRef]
- Li, X.Y.; Chen, X.G.; Cha, D.S.; Park, H.J.; Liu, C. Microencapsulation of a probiotic bacteria with alginate–gelatin and its properties. J. Microencapsul. 2008, 26, 315–324. [Google Scholar] [CrossRef]
- Vejan, P.; Abdullah, R.; Khadiran, T.; Ismail, S. Encapsulation of Bacillus salmalaya 139SI using Double Coating Biopolymer Technique. Lett. Appl. Microbiol. 2019, 68, 56–63. [Google Scholar] [CrossRef]
- He, Y.; Wu, Z.; Ye, B.-C.; Wang, J.; Guan, X.; Zhang, J. Viability evaluation of alginate-encapsulated Pseudomonas putida Rs-198 under simulated salt-stress conditions and its effect on cotton growth. Eur. J. Soil Biol. 2016, 75, 135–141. [Google Scholar] [CrossRef]
- Saberi Riseh, R.; Moradi Pour, M. The effect of Bacillus subtilis Vru1 encapsulated in –bentonite coating enriched with titanium nanoparticles against Rhizoctonia solani on bean. Int. J. Biol. Macromol. 2020, 152, 1089–1097. [Google Scholar] [CrossRef] [PubMed]
- Alfredo, M.S.; Aleli Cornelia, R.P. Biological control of sheath blight of upland rice with Trichoderma species. J. Trop. Plant Pathol. 2011, 69, 1–9. [Google Scholar]
- Lee, J.; Tan, W.; Ting, A. Revealing the antimicrobial and enzymatic potentials of culturable fungal endophytes from tropical pitcher plants (Nepenthes spp.). Mycosphere 2014, 5, 364–377. [Google Scholar] [CrossRef]
- Alexander, D.B.; Zuberer, D.A. Use of chrome azurol S reagents to evaluate siderophore production by rhizosphere bacteria. Biol. Fertil. Soils 1991, 12, 39–45. [Google Scholar] [CrossRef]
- Patten, C.L.; Glick, B.R. Bacterial biosynthesis of indole-3-acetic acid. Can. J. Microbiol. 1996, 42, 207–220. [Google Scholar] [CrossRef] [PubMed]
- Kasana, R.C.; Salwan, R.; Dhar, H.; Dutt, S.; Gulati, A. A Rapid and Easy Method for the Detection of Microbial Cellulases on Agar Plates Using Gram’s Iodine. Curr. Microbiol. 2008, 57, 503–507. [Google Scholar] [CrossRef]
- Maurhofer, M.; Keel, C.; Haas, D.; Défago, G. Influence of plant species on disease suppression by Pseudomonas fluorescens strain CHAO with enhanced antibiotic production. Plant Pathol. 1995, 44, 40–50. [Google Scholar] [CrossRef]
- Omidvari, M. Biological Control of Fusarium solani, the Causal Agent of Damping off, by Fluorescent Pseudomonads and Studying Some of Their Antifungal Metabolite Productions on It. Master’s Thesis, Tehran University, Tehran, Iran, 2015; p. 94. (In Persian). [Google Scholar]
- Krasaekoopt, W.; Bhandari, B.; Deeth, H.C. Survival of probiotics encapsulated in chitosan-coated alginate beads in yoghurt from UHT- and conventionally treated milk during storage. LWT 2006, 39, 177–183. [Google Scholar] [CrossRef]
- Saberi-Riseh, R.; Moradi-Pour, M. A novel encapsulation of Streptomyces fulvissimus Uts22 by spray drying and its biocontrol efficiency against Gaeumannomyces graminis, the causal agent of take-all disease in wheat. Pest Manag. Sci. 2021, 77, 4357–4364. [Google Scholar] [CrossRef]
- Kloepper, J.W.; Leong, J.; Teintze, M.; Schroth, M.N. Enhanced plant growth by siderophores produced by plant growth-promoting rhizobacteria. Nature 1980, 286, 885–886. [Google Scholar] [CrossRef]
- Challis, G.L.; Hopwood, D.A. Synergy and contingency as driving forces for the evolution of multiple secondary metabolite production by Streptomyces species. Proc. Natl. Acad. Sci. USA 2003, 100, 14555–14561. [Google Scholar] [CrossRef] [PubMed]
- Shih-Yung, H. IAA Production by Streptomyces Scabies and Its Role in Plant Microbe Interaction. Master’s Thesis, Cornell University, Ithaca, NY, USA, 2010. [Google Scholar]
- Vejan, P.; Abdullah, R.; Khadiran, T.; Ismail, S.; Boyce, A.N. Role of Plant Growth Promoting Rhizobacteria in Agricultural Sustainability—A Review. Molecules 2016, 21, 573. [Google Scholar] [CrossRef] [PubMed]
- Egamberdieva, D. Indole-acetic acid production by root associated bacteria and its role in plant growth and development. In Auxins: Structure, Biosynthesis and Functions; Keller, A.H., Fallon, M.D., Eds.; Nova Science Publishers: Hauppauge, NY, USA, 2011; pp. 1–14. [Google Scholar]
- Datta, C.; Basu, P. Indole acetic acid production by a Rhizobium species from root nodules of a leguminous shrub Cajanus cojan. Microbiol. Res. 2000, 155, 123–127. [Google Scholar] [CrossRef]
- Ahmed, A.; Hasanian, S. Auxins as one of the factors of plant growth improvement by plant growth promoting rhizobacteria. Pol. J. Microbiol. 2014, 63, 261–266. [Google Scholar] [CrossRef]
- Yarullina, L.G.; Akhatova, A.R.; Kasimova, R.I. Hydrolytic enzymes and their proteinaceous inhibitors in regulation of plant–pathogen interactions. Russ. J. Plant Physiol. 2016, 63, 193–203. [Google Scholar] [CrossRef]
- Keel, C.; Defago, G. Interactions between beneficial soil bacteria and root pathogens: Mechanisms and ecological impact. In Multitrophic Interactions in Terrestrial System; Gange, A.C., Brown, V.K., Eds.; Blackwell Science Oxford, UK: 1997; pp. 27–47.
- Çabuk, B.; Tellioglu, H. Protection of Lactobacillus acidophilus NRRL-B 4495 under in vitro gastrointestinal conditions with whey protein/pullulan microcapsules. J. Biosci. Bioeng. 2015, 120, 650–656. [Google Scholar] [CrossRef]
- Coates, J. Interpretation of Infrared Spectra, a Practical Approach. In Encyclopedia of Analytical Chemistry; Meyers, R.A., Ed.; John Wiley & Sons Ltd.: Chichester, UK, 2000; pp. 10815–10837. [Google Scholar]
- Barka, E.A.; Vatsa, P.; Sanchez, L.; Gaveau-Vaillant, N.; Jacquard, C.; Klenk, H.-P.; Clément, C.; Ouhdouch, Y.; van Wezel, G.-P. The Actinobacteria: Taxonomy, Physiology and their natural products. Microbiol. Mol. Biol. Rev. 2016, 80, 1–43. [Google Scholar] [CrossRef]
- Getha, K.; Vikineswary, S.; Wong, W.H.; Seki, T.; Ward, A.; Goodfellow, M. Evaluation of Streptomyces sp. strain g10 for suppression of Fusarium wilt and rhizosphere colonization in pot-grown banana plantlets. J. Ind. Microbiol. Biotechnol. 2005, 32, 24–32. [Google Scholar] [CrossRef]
- Errakhi, R.; Bouteau, F.; Lebrihi, A.; Barakate, M. Evidences of biological control capacities of Streptomyces spp. against Sclerotium rolfsii responsible for damping-off disease in sugar beet (Beta vulgaris L.). World J. Microbiol. Biotechnol. 2007, 23, 1503–1509. [Google Scholar] [CrossRef]
- El-Tarabily, K.A.; Sivasithamparam, K. Non-streptomycete actinomycetes as biocontrol agents of soil-borne fungal plant pathogens and as plant growth promoters. Soil Biol. Biochem. 2006, 38, 1505–1520. [Google Scholar] [CrossRef]
- Sarwar, A.; Latif, Z.; Zhang, S.; Zhu, J.; Zechel, D.L.; Bechthold, A. Biological Control of Potato Common Scab With Rare Isatropolone C Compound Produced by Plant Growth Promoting Streptomyces A1RT. Front. Microbiol. 2018, 9, 1126. [Google Scholar] [CrossRef] [PubMed]
- Dias, M.P.; Bastos, M.S.; Xavier, V.B.; Cassel, E.; Astarita, L.V.; Santarém, E.R. Plant growth and resistance promoted by Streptomyces spp. in tomato. Plant Physiol. Biochem. 2017, 118, 479–493. [Google Scholar] [CrossRef] [PubMed]
- Cordovez, V.; Carrion, V.J.; Etalo, D.W.; Mumm, R.; Zhu, H.; van Wezel, G.P. Diversity and functions of volatile organic compounds produced by Streptomyces from a disease-suppressive soil. Front. Microbiol. 2015, 6, 1081. [Google Scholar] [CrossRef] [PubMed]
- Peyvandi, M.; Mirza, M.; Jamakani, Z.K. The effect of nano Fe chelate and Fe chelate on the growth and activity of some antioxidant. New Cell. Mol. Biotechnol. 2011, 2, 25–32. (In Farsi) [Google Scholar]
- Ma, J.F. Role of silicon in enhancing the resistance of plants to biotic and abiotic stresses. Soil Sci. Plant Nutr. 2004, 50, 11–18. [Google Scholar] [CrossRef]
- Gao, X.; Zou, C.; Wang, L.; Zhang, F. Silicon Decreases Transpiration Rate and Conductance from Stomata of Maize Plants. J. Plant Nutr. 2006, 29, 1637–1647. [Google Scholar] [CrossRef]
- Kardavan, G.; Karamian., R. The effects of titanium dioxide nanoparticles and spermine on physiological responses of licorice (Glycyrrhiza glabra L.) to cold stress. J. Plant Physiol. Breed. 2020, 10, 93–110. [Google Scholar]
- Lu, C.M.; Zhang, C.Y.; Wen, J.Q.; Wu, G.R.; Tao, M.Z. Research of the effect of nanometer materials on germination and growth enhancement of glycine max and its mechanism. Soybean Sci. 2002, 21, 168–171. [Google Scholar]
- Hastuti, R.D.; Lestari, Y.; Saraswati, R.; Suwanto, A. Chaerani Capability of Streptomyces spp. in Controlling Bacterial Leaf Blight Disease in Rice Plants. Am. J. Agric. Biol. Sci. 2012, 7, 217–223. [Google Scholar] [CrossRef][Green Version]
- Junaid, J.M.; Dar, N.A.; Bhat, T.A.; Bhat, A.H.; Bhat, M.A. Commercial Biocontrol Agents and Their Mechanism of Action in the Management of Plant Pathogens. Int. J. Mod. Plant Anim. Sci. 2013, 1, 39–57. [Google Scholar]

| N° | Treatments | ||
|---|---|---|---|
| S. fulvissimus Uts22 | |||
| Free | Encapsulated | Wheat Seeds with P. aphanidermatum | |
| T1 | 10 mL | 0 | 0 g |
| T2 | 10 mL | 4 g | |
| T3 | 10 g | 0 g | |
| T4 | 10 g | 4 g | |
| T5 | 4 g | ||
| T6 | Microcapsules without bacterium | ||
| T7 | Control | ||
| Characteristic Group | Wavelength (cm−1) | |
|---|---|---|
| ALG | AG | |
| C—O stretch | 1126 | 1022 |
| C—O—C stretch | 1320 | - |
| C=C stretch | - | - |
| C=O stretch | 1619 | 1608 |
| C—H stretch | 2921 | 2923 |
| O—H stretch | 3449 | 3424 |
| C(=O)—O stretch | 1421 | 1618 |
| Treatments | SF (g) | SD (g) | RF (g) | RD (g) | |
|---|---|---|---|---|---|
| T1 | S. fulvissimus Uts22 bacteria | 15.76 c | 5.27 c | 14.28 c | 4.31 c |
| T2 | S. fulvissimus Uts22 bacteria + P. aphanidermatum | 15.16 d | 5.27 d | 14.28 c | 4.31 c |
| T3 | S. fulvissimus Uts22 microcapsules | 17.6 a | 6.24 a | 15.36 a | 5.28 a |
| T4 | S. fulvissimus Uts22 microcapsules + P. aphanidermatum | 16.11 b | 5.98 b | 15.08 b | 5.06 b |
| T5 | P. aphanidermatum | 8.11 g | 1.82 g | 9.11 f | 2.15 g |
| T6 | Microcapsule without bacteria | 14.23 e | 3.95 e | 13.94 d | 3.29 e |
| T7 | Control | 12.08 f | 3.06 f | 11.19 e | 3.11 f |
Publisher’s Note: MDPI stays neutral with regard to jurisdictional claims in published maps and institutional affiliations. |
© 2022 by the authors. Licensee MDPI, Basel, Switzerland. This article is an open access article distributed under the terms and conditions of the Creative Commons Attribution (CC BY) license (https://creativecommons.org/licenses/by/4.0/).
Share and Cite
Saberi Riseh, R.; Moradi Pour, M.; Ait Barka, E. A Novel Route for Double-Layered Encapsulation of Streptomyces fulvissimus Uts22 by Alginate–Arabic Gum for Controlling of Pythium aphanidermatum in Cucumber. Agronomy 2022, 12, 655. https://doi.org/10.3390/agronomy12030655
Saberi Riseh R, Moradi Pour M, Ait Barka E. A Novel Route for Double-Layered Encapsulation of Streptomyces fulvissimus Uts22 by Alginate–Arabic Gum for Controlling of Pythium aphanidermatum in Cucumber. Agronomy. 2022; 12(3):655. https://doi.org/10.3390/agronomy12030655
Chicago/Turabian StyleSaberi Riseh, Roohallah, Mojde Moradi Pour, and Essaid Ait Barka. 2022. "A Novel Route for Double-Layered Encapsulation of Streptomyces fulvissimus Uts22 by Alginate–Arabic Gum for Controlling of Pythium aphanidermatum in Cucumber" Agronomy 12, no. 3: 655. https://doi.org/10.3390/agronomy12030655
APA StyleSaberi Riseh, R., Moradi Pour, M., & Ait Barka, E. (2022). A Novel Route for Double-Layered Encapsulation of Streptomyces fulvissimus Uts22 by Alginate–Arabic Gum for Controlling of Pythium aphanidermatum in Cucumber. Agronomy, 12(3), 655. https://doi.org/10.3390/agronomy12030655







